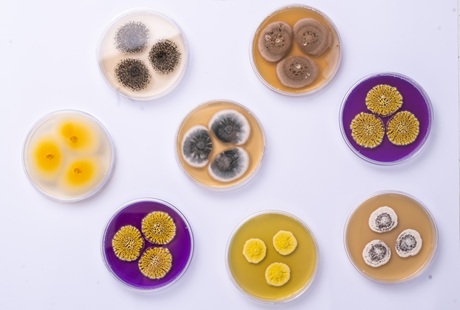
Plísně Plísně

Plísně jsou vděčné téma, nikoho nenechají chladným, říká mykolog
03. 09. 2025
V dětství se toužil stát třeba cestovatelem nebo mnichem, jenže láska k přírodě byla silnější než touha po klidu v klášteře. Vedle studia botaniky si „střihnul“ ještě medicínu. Na škole ho ale nakonec pohltil svět mikroskopických hub. A jedna už se po něm i jmenuje. „Překvapilo mě, jak moc se o Aspergillus hubkae zajímala média. Pro mě jako introverta, který se nejraději schovává někde v laborce, to byl naprostý mazec,“ říká v rozhovoru pro A / Magazín Vít Hubka z Mikrobiologického ústavu AV ČR.
Máte rád smaženici?
Jistě! Houby miluju na všechny způsoby. Některé druhy jsou vysloveně výborné. Například takový smrž je v jídle naprosto luxusní. Baví mě i bloumat s košíkem po lese a hledat, nicméně houbař jsem spíš sváteční a hlavně dost průměrný. Sbírám jen hřibovité kousky – v těch ostatních se moc nevyznám, tak raději sázím na jistotu. I když jsem mykolog, lesní houby nejsou zrovna moje parketa.
Z těch, které zkoumáte, se třeba omáčka asi uvařit nedá.
Rozhodně ne. Zabývám se mikroskopickými houbami ohrožujícími lidské zdraví. Napadají vnitřní orgány imunitně oslabených jedinců nebo mají na svědomí kožní onemocnění, se kterými se někdy potká skoro každý z nás.
A nebývají to moc příjemná setkání.
Je pravda, že kožní mykózy sice nezabíjejí, ale dokážou člověku slušně znepříjemnit život. Jde přitom o jedny z nejběžnějších infekcí vůbec – podle odhadů momentálně trpí nějakou formou až čtvrtina světové populace. V různých oblastech světa se však daří trochu jiným typům mykóz. Částečně je to i tím, že některé patogeny jsou úzce specializované a vybírají si třeba jen konkrétní etnickou skupinu, pohlaví nebo určitou část těla.

Spíše než lesním houbám rozumí Vít Hubka těm mikroskopickým. (CC)
Houby jsou natolik nekorektní?
Zdá se, že ano. (úsměv) Ale důvody jsou spíše biologické a kulturní než genderové či etnické. Roli hrajou například odlišná stavba vlasu u různých etnik, preference některých účesů nebo anatomické a hormonální rozdíly mezi muži a ženami. V rozvojových zemích jsou stále časté některé typy nákaz vlasaté části hlavy, které už se v Evropě prakticky vymýtily – mimo jiné díky lepší dostupnosti antimykotik a kvalitnější lékařské péči. Patogeny, které vymizely, ale nahradily jiné, lépe přizpůsobené měnícím se návykům hostitele – tedy člověka. Rozšíření dermatofytů, jak se původcům kožních mykóz říká, se zkrátka mění v čase a souvisí s kulturními odlišnostmi, ale i s proměnami životního stylu a hygienických standardů.
Naše prarodiče tedy obtěžovaly jiné druhy než nás teď?
V podstatě ano. Dermatofyty se vyznačují tím, že dokážou rozkládat keratin v kůži a využívat ho jako svůj hlavní zdroj živin. V přírodě na to mají tak trochu monopol, protože tento odolný protein téměř žádné jiné organismy štěpit nedovedou. Nemají tedy konkurenci, takže o své místo na kůži bojují jen jednotlivé druhy hub mezi sebou. Kdo líp odhadne chování a koníčky hostitele, vyhrává a postupně obsadí území.
Úplná občanská válka plísní. Vrtá mi ale hlavou, jak s jejich boji souvisejí koníčky napadeného.
Zásadně. Některým druhům dermatofytů se třeba dobře daří ve vlhkých místech, jako jsou bazény, posilovny, sportoviště a sauny. V polovině minulého století mělo u nás jimi způsobené mykózy minimum lidí, rozšířily se až s nárůstem obliby těchto volnočasových aktivit. Stačí ve sprše šlápnout na infikovanou kožní šupinu a…
… houba vyklíčí na chodidle dalšího člověka.
Přesně tak. Nohy pak pálí a svědí, olupují se nebo mokvají a praskají mezi prsty. Jestliže se plíseň neléčí, může napadnout i nehty a způsobit takzvanou onychomykózu. Nakažený nehet změní barvu i strukturu, často je ztluštělý a drolivý. Pokud se nenasadí medikace, houba ho časem v podstatě celý sežere.

Porovnání nehtu postiženého onychomykózou a zdravého nehtu
To si snad ani nechci představovat…
Chápu, takový nehtík vypadá dost odpudivě. Když ale pozorujete patogen, který ho znetvořil, v kultuře nebo pod mikroskopem, je to často nádhera. Sledujete krásné struktury a nestačíte se divit. Člověk si jen musí odmyslet nehet a celý příběh okolo. (smích) Mimochodem, infekcí nehtů se lidé většinou snaží zbavit měsíce i roky. A mezi staršími lidmi u nás dominují.
Které další aktivity přejí mykózám?
Třeba bojové sporty. Zejména u mužů ve věku dvacet až čtyřicet let, kteří se jim věnují, prosperují specifické druhy dermatofytů. K přenosu potřebují intenzivní tělesný kontakt, ale šíří se zřejmě i prostřednictvím kontaminovaných žíněnek a náčiní. Lehce rizikové hobby je ale i zahradničení. Dermatofyty totiž žijí i v půdě, kde rozkládají keratin, který se tam dostal z oloupané kůže, srsti, peří, uhynulých zvířat nebo výkalů masožravců. Když se tedy někdo často hrabe v hlíně, může narazit na jejich spory a nakazit se.
Takže ani v záhonu není bezpečno…
Nebojte se, infekce z půdy jsou spíš výjimečné. Mnohem častější jsou však ty, které na nás přenášejí domácí zvířata. Tedy zejména na děti, dospívající a mladé ženy, které s nimi bývají v nejužším kontaktu. Mykózy zpravidla dostanou od koček, psů, králíků a v posledních letech hlavně od morčat.
Morčata jsou tolik v kurzu?
Mezi dětmi celkem frčí, ale infekcí od těchto hlodavců přibylo hlavně proto, že se v průběhu let změnil jejich přirozený patogen. Teď je mnohem nakažlivější než dříve. Myslíme si, že byl do střední Evropy zavlečen pravděpodobně kolem roku 2010 z Ameriky a rychle se rozšířil v chovech. V roce 2017 ho například němečtí vědci našli u devadesáti procent morčat ve zverimexech napříč Berlínem. U nás jde nyní o úplně nejběžnějšího původce kožních mykóz, které se přenášejí ze zvířat na člověka. Před patnácti lety byl přitom v Česku skoro neznámý.

Čím dál častěji se u lidí objevují infekce kůže přenesené z domácích mazlíčků, hlavně z morčat. (CC)
Kolik nešťastníků s ním už mělo tu čest?
To se těžko odhaduje. Deset let jsme s kolegy mapovali rozšíření dermatomykóz v tuzemsku a za tu dobu se k nám od spolupracujících pracovišť dostalo přes tisíc případů „morčecí infekce“, hlavně u dětí. Jenže naše studie představuje jen malý vzorek, takže skutečný počet nákaz bude mnohanásobně vyšší. Zajímavé je, že v únoru a březnu jsou v našich statistikách každoročně počty nakažených dětí nejvyšší.
Na jaře se houbě daří nejvíc?
Kdepak, tím to není. Morčata jsou oblíbený vánoční dárek. Přestože se s nimi děti začnou muchlovat už pod stromkem, obvykle chvilku trvá, než se na ně dermatofyt přenese a než se objeví symptomy, které rodiče donutí vyrazit k lékaři. Do laborky tak vzorky doputují se zpožděním týdnů až měsíců od pořízení zvířete.
Kdy tedy mám jako majitel morčete a rodič zpozornit?
Pokud se na kůži vašeho potomka objeví ohraničené zarudlé léze, které se olupují, mají vyvýšený okraj, postupně se zvětšují a většinou svědí. Nejčastěji bývají na končetinách, obličeji, krku nebo trupu. Pediatři už o tomto onemocnění i díky naší letité osvětě celkem dobře vědí, a když vidí podobné projevy, hned se rodičů ptají: „Nemáte doma morčátko? Nebo kočku, psa či ježka?“ Nákaz ježčím patogenem totiž v posledních letech taky výrazně přibylo.
Počkejte, lidi si teď domů pořizují i ježky?
Ano, tento trend u nás začal zhruba před deseti lety. Respektive v té době jsme zaznamenali první infekce přenesené z ježků na lidi. Člověk od nich díky bodlinám mykózu chytne poměrně jednoduše – škrábanec totiž usnadní průnik houby do kůže. Na ní pak vzniknou obdobné léze jako v případě nákaz od morčat.

Ježci u dětí stoupají v oblibě, jejich bodliny ale usnadňují přenos nákazy.
A tato „paráda“ pak koluje v rodině a školách.
Naštěstí ne. Infekce ze zvířat už se pak nepředává mezi lidmi dál. Tyto patogeny totiž nejsou na přenos z člověka na člověka dobře adaptované. Dovedou nám sice nemoc způsobit, ale pro houbu je to většinou konečná. Mezi zvířaty se ale šíří snadno, hlavně ve velkých chovech. Jejich léčbě se však často nevěnuje dostatečná pozornost, což se snažíme zlepšit v našem aktuálním projektu. Lidem s diagnostikovanou mykózou zvířecího původu budeme proplácet mykologické vyšetření jejich mazlíčků u veterináře, aby se identifikoval zdroj nákazy a zamezilo se dalšímu šíření infekce.
Co když prahneme po morčeti nebo ježkovi, ale plíseň bychom si raději odpustili?
Můžete si po nákupu zvířete vyšetření u zvěrolékaře zaplatit. Stojí obvykle mezi pěti sty až tisícem korun. Další možností je preventivní karanténa nebo koupele v šamponu s antimykotiky, který většinu případných patogenů docela spolehlivě zničí. Morčeti ani ježkovi přitom nijak zvlášť neublíží.
Bodliny se dají šamponovat?
Taky jsem se divil, ale dají. A funguje to až překvapivě dobře. Jednou jsme získali odběry z ježků z výstavy, před kterou majitelé ostnáče umyli v antimykotických přípravcích, a nenarazili jsme ani na jediný pozitivní vzorek s patogenem. V některých chovech jsme ho přitom vykultivovali téměř ze všech ježků.
Svědivá popraskaná chodidla, ztluštělé drolivé nehty, červené fleky na těle… Jak se kožní mykózy léčí?
Pacientovi se nasadí antimykotika – lokálně na kůži, nebo v tabletách. Tyto medikamenty většinou zlikvidují téměř všechny druhy dermatofytů. Přesné určení původce před nasazením léčby tedy zpravidla není nezbytně nutné. Některé houby však začínají být k běžným léčivům rezistentní.
Nepůsobí na ně?
Přesně tak. Jeden typ rezistence k nám zřejmě přišel z jihovýchodní Asie, zejména z Indie, kde jsou volně prodejné masti obsahující koktejl antimykotik, antibiotik a kortikosteroidů. Místní lidi se jimi léčí metodou pokus–omyl, takže se tam vyvinula rezistence, která se postupně rozšířila i do Evropy a Ameriky. U nás je její úroveň stále nízká, ale situace si rozhodně zaslouží pozornost, protože se může rychle změnit.
|
Čichám, čichám plíseň Kožní mykózy jsou tak trošku cítit. Zatímco běžný smrtelník však jejich odér nejspíš nezaznamená, pro nos elektronický by to mohlo být snadné. Právě na výzkumu směřujícímu k vývoji takového zařízení teď kolegové Víta Hubky v Mikrobiologickém ústavu AV ČR pracují. Zjistili totiž, že jednotlivé druhy patogenních hub, které způsobují infekce kůže, produkují různé těkavé látky. „Citlivý přístroj by tak mohl přímo na těle pacienta během chvilky ‚vyčuchat‘ původce nemoci. Lékař by okamžitě nasadil vhodnou léčbu, aniž by musel celé dny či týdny čekat na výsledky kultivace vzorku,“ popisuje vědec. |
Obývají naše tělo i houby neškodné?
Jistě, pokrývají třeba kůži i trávicí trakt. Jsme jimi v podstatě obrostlí stejně jako všechno kolem nás.
Kolik druhů hub na světě existuje?
Odhady se dost různí. Někdo udává kolem milionu, jiní autoři uvádějí i desetinásobek. Sám jsem se definici druhu a taxonomii hub věnoval a na základě svých zkušeností se kloním spíš k nižším číslům. Variabilita v rámci druhů hub je dle mého názoru mnohem větší, než se obecně předpokládá. I proto jsme v posledních letech s kolegy nejen popisovali druhy nové, ale dost jsme jich taky rušili, a systém tak zjednodušovali.
Těch nových jste za dvanáct roků zkoumání objevil zhruba stovku, většinu z nich tvořily takzvané kropidláky. Máte pro ně slabost?
Klasifikaci rodu Aspergillus, jak se kropidlákům latinsky říká, jsem se věnoval většinu kariéry. V současnosti vědci uznávají necelých pět stovek druhů těchto hub. Fascinující jsou mimo jiné tím, že neznají hranic. Najdete je téměř všude. Kdybyste teď v místnosti, kde sedíme, odebrala vzorek vzduchu, objevíte v něm spoustu jejich spor. Využívají se v biotechnologiích, farmacii i k fermentaci některých potravin, zejména těch asijských.
Jakých například?
Aspergillus oryzae se uplatňuje při výrobě sójové omáčky. S jeho pomocí taky kvašením rýže vzniká saké. Jiné kropidláky zase stojí za vznikem japonské pálenky šočú nebo třeba čínského fermentovaného čaje pu-erh. Některé druhy jsou však patogenní a napadají zejména lidi s oslabenou imunitou. Když je takový jedinec vdechne, houby se mu můžou usídlit v plicích nebo jiných orgánech, které se stanou doslova substrátem pro výživu kropidláků.

Jeden z druhů kropidláka, Aspergillus oryzae, se využívá například při fermentaci sójových bobů.
Právě v plicích jednoho íránského pacienta s tuberkulózou objevili loni zahraniční mikrobiologové dosud neznámý druh kropidláka, který pojmenovali po vás: Aspergillus hubkae. Proč vybrali zrovna vaše jméno?
Asi měli pocit, že jsem pro klasifikaci kropidláků udělal za krátkou dobu hodně. Byl jsem totiž ve světě lékařské mykologie a taxonomie v posledních letech poměrně dost vidět. Nebo je jenom nenapadlo nic lepšího… (úsměv)
Konzultovali to s vámi předem?
Ne, do poslední chvíle jsem o jejich záměru nic netušil. Dozvěděl jsem se to náhodou, když mi jeden kolega napsal esemesku, jestli vím, že mám mezi kropidláky jmenovce. Myslel jsem, že jde jen o nějaký vtip, jenže autoři objevu mi těsně před zveřejněním studie taky napsali, jestli s pojmenováním souhlasím. Publikace byla už v té době přijatá a nešlo nic moc namítat.
Vy byste snad protestoval? Nelichotilo vám to?
Docela mě to potěšilo, ale taky jsem byl v rozpacích. Nejsem totiž velkým příznivcem pojmenovávání hub po žijících vědcích. V minulosti už se stalo, že se ona osoba později třeba znelíbila veřejnosti. Jenže té houbě už kontroverzní jméno nikdo neodpáře. V sedmatřiceti jsem to zkrátka vnímal jako pořádný závazek.
Na druhou stranu, kolik lidí má v tom věku vlastní houbu…
Však já si toho vážím, jen jsem něco takového nečekal tak brzo. Většinou se to totiž dělá na počest vědců na konci kariéry nebo posmrtně. Možná mi tak kolegové chtěli vzkázat, že už bych měl pomalu jít od válu. (smích)
Nebo prostě jen chtěli ocenit vaši práci.
Snad ano. Nejvíc mě překvapilo, jak moc se o Aspergillus hubkae zajímala média. Pro mě jako introverta, který se nejraději schovává někde v laborce, to byl naprostý mazec. Skoro tři měsíce jsem dával rozhovory. Nikdy by mě třeba nenapadlo, že to dotáhnu až do Blesku. Mimochodem, tím jsem si definitivně získal respekt babičky a dalších příbuzných. Myslím, že to byl jeden z momentů, kdy si naplno uvědomili, že moje práce má smysl a ohlas.

Kolonie druhu Aspergillus hubkae kultivované v různých agarových médiích
Jste tedy první mykolog v rodině?
Ano. Maminka je švadlena a táta pracuje ve stavebnictví, takže můj obor je jim velmi vzdálený. Vždycky chtěli, abych se stal právníkem nebo lékařem. Já si ale vydupal botaniku, z čehož tenkrát nebyli moc nadšení. Jenže pro mě byla příroda jasná volba.
Odjakživa?
Jako dítě jsem chtěl být ještě vynálezcem a cestovatelem. Naši mi ale vysvětlili, že ježdění po světě není povolání, protože výpravy musí někdo platit. Docela dlouho mě taky lákalo stát se mnichem. Měl jsem totiž trochu problém s komunikací s ostatními lidmi a myslel si, že mnichy nikdo neotravuje, s nikým se nehádají, jsou pořád v klidu a žijí si podle sebe někde v lese mimo civilizaci. Zdálo se mi to jako ideální svět pro mě.
Celkem neobvyklý dětský sen. Do kolika let vás to táhlo do kláštera?
Na gymplu už mě moje mnišské představy přešly. Ale musím přiznat, že když jsem měl před pár lety těžké období a nevěděl, kudy kam, málem jsem tu myšlenku oprášil. Nakonec jsem to ale zvládl i bez mnišské kutny. Pomohlo mi mimo jiné dlouholeté chození na psychoterapii a taky návrat k přírodě, kterou jsem spoustu let zanedbával. Odmala mě fascinovala. Vyrůstal jsem na Lounsku ve vesnici zhruba o stovce obyvatel, kde žilo minimum dalších dětí. Byl jsem tedy hodně venku nebo v lese – často s dědou myslivcem, babičkou nebo sám.
Už tehdy vás braly houby?
Nijak zvlášť. Bavily mě hlavně kytky a zvířata. Když jsem se nepotuloval po lese, ležel jsem v encyklopediích o přírodě. Ve školce mě učitelky pořád chválily, že poznám každou rostlinku a brouka. Dělalo mi to hrozně dobře, tak jsem chtěl vědět víc a víc.
Vaši vědeckou dráhu tedy nakoply učitelky z mateřinky.
Tak trochu. Studium přírodovědy a botaniky na vysoké mě pak ale v počátcích spíš zklamalo. Chtěl jsem s ním proto po bakaláři seknout a odejít na medicínu, kam jsem složil přijímačky. Když už jsem byl ve fázi odcházení, shodou náhod jsem se nachomýtl k možnosti identifikovat houby z nakažených nehtů pro dermatologickou kliniku. A to mě nadchlo natolik, že jsem se rozhodl na botanice, kde se mykologie studuje, zůstat.

Už odmala to Víta Hubku táhlo k přírodě. Později ze studijních oborů vyhrála botanika, respektive mykologie. (CC)
Takový plesnivý nehet zjevně člověka uhrane…
Jak už jsem říkal, pod mikroskopem plísně vypadají úchvatně! Věnovat se houbám na lidském těle mi přišlo i užitečné, navíc šlo o elegantní propojení mykologie s medicínou.
Tu jste nakonec vedle botaniky rovněž absolvoval. Docela vražedná kombinace, ne?
Vražedný byl hlavně závěr studií. Medicína mě totiž od začátku zajímala hlavně v teoretické rovině, takže když došlo na praxe v nemocnicích, trpěl jsem. Postupem času jsem ztratil motivaci, protože už jsem věděl, že se léčením lidí živit nebudu. Bylo mi nicméně líto studium nedokončit, tak jsem se hecnul. Poslední dva ročníky bych si už ale napodruhé odpustil. Se všemi odklady mi zabraly asi šest let. Kdybych se mohl vrátit v čase, raději bych medicínu nedostudoval.
Znalosti „doktořiny“ se vám teď ale hodí.
Ano, lékařská mykologie, které se věnuju, je vlastně průnik mých dvou oborů. Mít před jménem MUDr. navíc v Česku rozhodně není k zahození – hodně lidí tady na tituly dost dá a koneckonců i lékaři, se kterými spolupracujeme, mě díky tomu víc berou.
Houbové příjmení vám zase jistě dělá čest mezi mykology. Mělo taky nějaký vliv na výběr vašeho směřování?
Vůbec ne. Když jsem pátral po jeho etymologii, zjistil jsem, že s houbou ani nemá nic společného. Údajně je odvozené od slova huba ve významu „člověk s výraznými rty“. Lidi se mě na moje nomen omen ale pochopitelně často ptají a musím říct, že to funguje jako dobrý konverzační icebreaker. Hned je zkrátka o čem mluvit. Než se teda hovor stočí na plísně…
Stává se to často?
Prakticky pořád. Nevěřila byste, jak vděčné je to téma. V každém totiž vyvolá nějaké emoce. A to mě na plísních hrozně baví. Když lidem řeknu, čím se zabývám, v první chvíli většinou reagují lehce zhnuseně. Vzápětí ale následuje nějaký příběh z jejich okolí, dotaz na nehet jejich babičky nebo mykózu jejich mazlíčka.
„Houby pod mikroskopem jsou krásné,“ tvrdí Vít Hubka.
Poněkud netradiční small talk…
Že? Plísně prostě nenechávají nikoho chladným. Ani nás v laboratoři. Když si čteme u žádanek na mykologické vyšetření anonymní lékařské zprávy, v nichž doktoři zkratkovitě líčí, jak pacienti mohli podle svých slov k patogenu přijít nebo jak se ho snažili zbavit, nestačíme se divit a občas taky prskáme smíchy.
Pobavte i nás!
Někdy jde o celkem bizarní příběhy, kdy třeba pacientka tvrdí, že infekci chytila od kamarádky, která ji pokousala. Jindy se zase člověk dozví o aktivitách, o jejichž existenci neměl ani tušení, jako jsou dětské turnaje ve wrestlingu nebo návštěvy kočičích kaváren. I v léčbě bývají lidé hodně invenční: plísně ve vlasech se například snaží zbavit savem, což vážně nedoporučuju. Někdy je to ale taky dost děsivé čtení. Když lidi usoudí, že se mohli nakazit od svého zvířete, odloží klidně do té chvíle největšího miláčka rodiny k popelnicím, pustí ho do přírody, nebo dokonce hodí do kotle. Vzpomínám si i na agamu, kterou majitel bez mrknutí oka spláchl do záchodu. Od ještěrů přitom člověk žádnou mykózu ani chytit nemůže.
To je síla. Jak si od takových historek čistíte hlavu?
Nejraději odpočívám v sauně. A nebojte – nejde o profesionální deformaci, plísně tam cíleně nelovím. I když zrovna nedávno jsem si z ní jednu přinesl, takže než ji zaléčím, mám s tímto koníčkem utrum. (smích) Saunování mě chytilo na stáži v Japonsku, kde jsem strávil dva roky. Tam jsem do sauny chodil i čtyřikrát týdně, tady už se k téhle své zálibě většinou dostanu v sezoně jen dvakrát do týdne. Vedro a následný šok ze skoku do ledové vody mi dělá hrozně dobře. Líbí se mi i saunové ceremoniály, což je takové divadlo, které vám má pobyt ve vedru zpříjemnit. Hlavně ale odvede vaši pozornost a vy si díky tomu ani nevšimnete, že se ještě zvedla teplota, a vydržíte déle.
A pak hned šup do vody.
Jen to zasyčí. Vedle saunování vypnu i nad knížkou, u badmintonu a ping-pongu, při přesazování kytek, v houpací síti na terase nebo během procházek Prahou. Bydlím teď pod Vyšehradem, kousek od Vltavy. S přítelem se moc rádi potulujeme po okolí. Taky miluju horskou turistiku. Loni jsem se třeba na šest týdnů vrátil do Japonska prozkoumat tamní „kopečky“. Tahle dovolená ale neskončila zrovna podle představ…

K velkým koníčkům Víta Hubky patří sauna. V minulosti do ní chodil i čtyřikrát týdně. (CC)
Co se přihodilo?
Lezl jsem po sopkách, jenže na sypkém terénu jsem podklouzl a spadl. V Česku mi pak řekli, že mám zpřetrhané vazy v obou kotnících. To jsem ale v té chvíli netušil, tak jsem se po svých nějak dobelhal zpět do civilizace. Zbývalo ještě deset dní do návratu, tak jsem se holt z hor přesunul na pláž a sledoval, jak mi nohy natékají do sloních rozměrů a hrají všemi barvami.
Podnikáte podobně dobrodružné výpravy často?
Ani ne, do zahraničí ale jezdím několikrát do roka. Většinou však kvůli vědeckým konferencím, kde to pochopitelně není taková divočina. Dostal jsem se ale díky nim do zemí, kam bych se jako běžný turista jen tak nepodíval. Letos už jsem třeba navštívil Brazílii, Keňu a Jihoafrickou republiku. A to v jediném měsíci.
Koukám, že dětský sen stát se cestovatelem jste si díky vědě taky částečně splnil.
Dá se to tak říct. Být pořád pryč už mě ale tolik neláká. Zakořenil jsem v Praze, mám tu svůj život – a svoje houby. I když ty, které zkoumám, patří spíš k záporným hrdinkám a pro většinu lidí jsou jejich projevy prostě „fuj“.
Když už je řeč o „záporačkách“, v kultovní počítačové hře The Last of Us i v její seriálové adaptaci houby napadají lidské mozky a mění své oběti v zombie s kanibalskými sklony. Hrozí něco takového i v reálu?
Nemyslím si. Tvůrci se sice inspirovali skutečným patogenem mravenců jménem Ophiocordyceps unilateralis, který je schopen prorůst organismus tohoto hmyzu a dokonale ho ovládnout, nicméně u savců se žádný podobný příklad manipulace houbou najít nedá.
Zrovna houbová pandemie by tedy lidstvo vyhladit neměla?
Ne, o to se spíš postaráme sami… Mimochodem, můj kolega Tomáš Větrovský pracoval od roku 2016 na hře se stejným motivem, aniž by o existenci The Last of Us tušil. Jeho verze se jmenuje Mycosis: Heroes of MBÚ a ona mravenčí houba v ní útočí na mozky vědců našeho ústavu. Hráči musejí najít zdroj nákazy a zachránit akademickou obec dřív, než se i z nich stanou krvelační „zombíci“ v bílém plášti. Zkusíte to taky? (úsměv)
|
MUDr. Mgr. Vít Hubka, Ph.D. Vyučuje mykologii na Přírodovědecké fakultě UK, zároveň působí v laboratoři genetiky a metabolismu hub Mikrobiologického ústavu AV ČR, kde mimo jiné zkoumá kožní mykózy přenesené ze zvířat na člověka. Dva roky strávil na výzkumné stáži v Japonsku. Loni po něm mezinárodní tým mykologů z Nizozemí a Íránu pojmenoval nový druh houby (Aspergillus hubkae) způsobující plicní onemocnění. V témže roce obdržel prémii Lumina quaeruntur. |
Rozhovor vyšel pod názvem Plísně jsou cool v A / Magazínu 2/2025:

2/2025 (verze k listování)
2/2025 (verze ke stažení)
Čtvrtletník A / Magazín vydává Akademie věd ČR. Výtisky zasíláme zdarma všem zájemcům. Kontaktovat nás můžete na adrese predplatne@ssc.cas.cz.
Text: Radka Římanová, Divize vnějších vztahů SSČ AV ČR
Foto: Jana Plavec, Divize vnějších vztahů SSČ AV ČR; Zhou et al. (2024) Mycopathologia 189; Shutterstock
 Text a fotografie označené CC jsou uvolněny pod svobodnou licencí Creative Commons.
Text a fotografie označené CC jsou uvolněny pod svobodnou licencí Creative Commons.
Přečtěte si také
- Moje komfortní zóna je v labu, říká neurovědkyně Monika Kubísková
- Reprodukční odysea aneb Jak chytit nejkvalitnější spermii
- Breberky mě fascinovaly odmala, říká mikrobiolog Michal Kraus
- Učíme se, vybavujeme si a zapomínáme. Co dokáže paměť a jak ji přelstít?
- Nádorové buňky jako zlodějky. Jak posílit imunitní systém, aby na ně vyzrál?
- Nová sloučenina chrání kostní buňky, může pomoci pacientům s cukrovkou
- Růst listů, kořenů, kvetení i rozmnožování aneb Za vším hledej hormon
- Řekni mi to vůní. Pachová komunikace řídí životy zvířat i lidí
- Luční kvítí klíčem k poznání evoluce. Vědci popsali DNA chromozomu Y
- Jak se mozek zotavuje po mrtvici? Odpovědi přináší studie českých vědců
 (CC)
(CC)